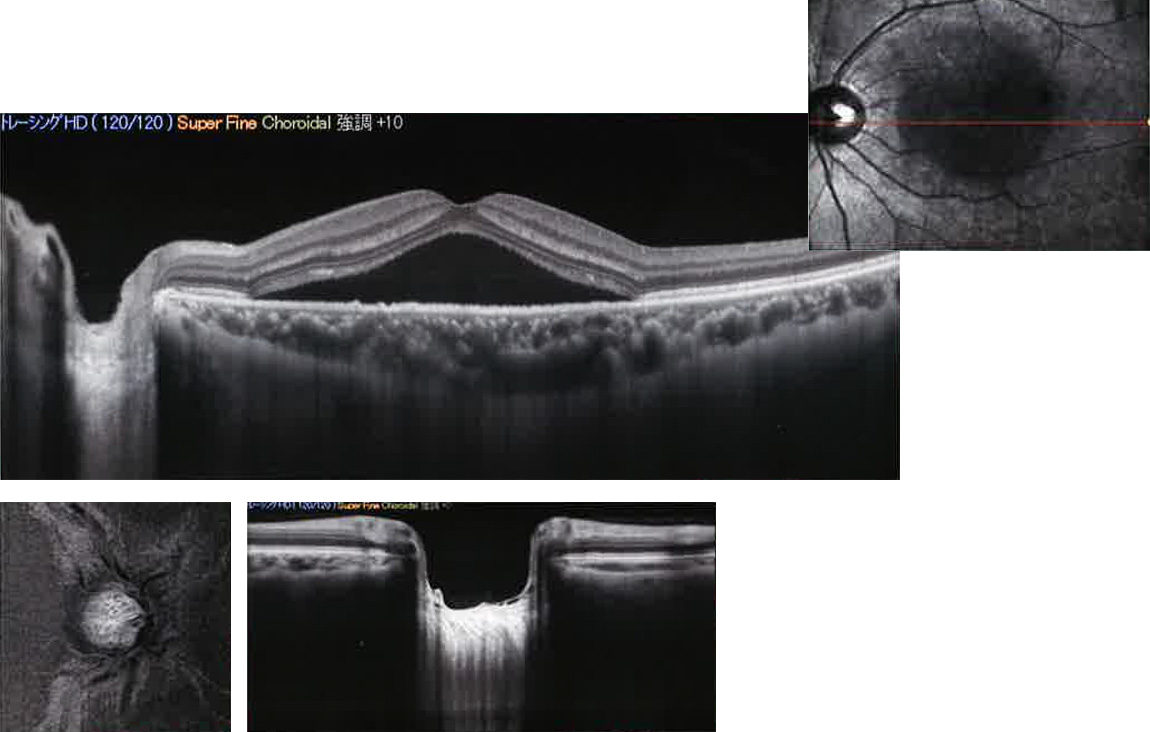

OCTアンギオグラフィー
OCTアンギオグラフィーについて

当院は最新型のOCT RS3000(Advance 2)を導入しております。当機種最大の特徴は、OCTアンギオグラフィーが搭載されたことです。
OCTアンギオグラフィーにより、詳細な新生血管や血管閉塞の評価ができるようになりました。
OCTアンギオグラフィーとは
OCTの技術を応用して、網膜血管、脈絡膜血管、新生血管等の構造を可視化し観察することができる最先端の技術です。造影検査のような造影剤を用いる必要がなく、患者さんにとっては少ない負担で検査を受けることが可能です。
OCT RS3000(Advance 2)による検査事例
~Advanced OCT~
新たに高速85,000A-Scans/秒を可能にするOCTカメラを採用し、「速さ」を進化させたRS-3000 Advance2は、幅広い網膜検査に対応します。
OCT-Angiographyの可能性を広げる新パノラマ機能

高速・高感度のOCTカメラを採用
新たなOCTカメラの採用により、 スキャン速度が85,000A-Scans/秒に向上しました。
また、従来モデル*2に比べ、スーパーファイン時の感度が1.6倍になりました。
*2 RS-3000 Advance

緑内障解析
ワイドエリアスキャン12×9mm

Progressionフォローアップ

最大50回分の撮影データを解析
長眼軸長正常眼データベース

OCT-AngiographyによるVascular imageスクリーニング
OCT-Angiographyによる無灌流領域の観察
OCT-Angiographyは、網膜の血流を非侵襲で画像化する技術です。
無灌流領域の検出や網膜微小血管まで精細に描出できることから眼循環の評価に有用です。

OCT-Angiographyで網膜毛細血管を観察
弊社独自のOCT-Angiography解析アルゴリズムであるCODAA*の特長は、赤血球などの血流細胞の動きをOCT信号の振幅と位相の両方を用いて算出している点です。このCODAA手法により、キャピラリーリングなどの微小な循環まで、より鮮明に描出が可能です。
※Complex OCT signal Difference Analysis Angiography

OCT-Angiographyで網膜毛細血管を観察
AMDでは、網膜外層と脈絡膜において新生血管を観察することに有用です。

OCT-Angiographyで網膜毛細血管を観察
AMDでは、OCT-AngiographyとEn faceを組み合わせてみることで、より病態把握に有用です。

SLO イメージ&トレーシングHD plus
最大120枚のHD(画像加算平均)処理を精度よくおこなうことができます。
スーパーファインモード*1と組み合わせることで網膜内層の繊細なコントラストを明瞭に描出します。
*1 被検眼の状態によってOCT感度を切り替えることで、よりクオリティの高い撮影画像を取得可能です。
高速撮影の「レギュラー」から、より高感度となる「ファイン」「スパーファイン」の3段階から選択可能です。

Choroidal OCT イメージ(EDI-OCT)
Choroidal OCT撮影をおこなうことで輝度の弱い深部の篩状板や脈絡膜をより明瞭に観察できます。
エンハンス機能 (硝子体ポケットイメージ)
撮影画像の微弱な信号を強調することで、硝子体や網膜などを明瞭に観察できます。

Multimodal imagingによる早期緑内障解析
黄斑マップ:緑内障 [NFL+GCL+IPL]
正常眼データベースで解析し両眼で表現することで、早期緑内障の変化や定量的な情報を直感的に表示します。
![黄斑マップ:緑内障 [NFL+GCL+IPL] 黄斑マップ:緑内障 [NFL+GCL+IPL]CL+IPL]](/library/5510d113135e870266000460/5c5a24b10192d483445810fa.jpg)
Progression フォローアップ(複数データの経過観察)
最大50回分の撮影データを解析し、経時的な変化を各種マップおよびチャートやトレンドグラフを用いて表示することが可能です。

黄斑解析

乳頭解析
タイムラプス機能
フォローアップ画面で表示した複数枚の画像データを自動でつなぎ合わせ、経時的変化を動画のように表示することができます。







